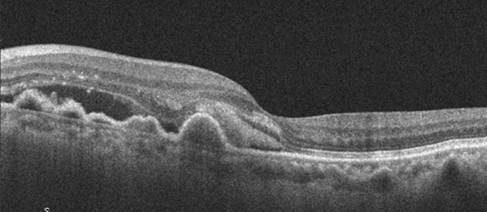
Miopía patológica: Tipos de miopía

MINIGUÍA PARA OPTOMETRISTAS
Miniguía Clínica: Degeneración Macular Asociada a la Edad (DMAE)
INTRODUCCIÓN
La degeneración macular asociada a la edad (DMAE) constituye la principal causa de pérdida visual irreversible en personas mayores de 50 años en países desarrollados. Esta realidad, que afecta a más de 196 millones de personas a nivel mundial [1], representa uno de los mayores desafíos que enfrentamos en la práctica optométrica diaria.
La DMAE no solo impacta la agudeza visual central, sino que transforma completamente la calidad de vida de nuestros pacientes. La lectura se vuelve imposible, el reconocimiento facial se deteriora y actividades cotidianas como cocinar o mirar el móvil se convierten en obstáculos difíciles de salvar. Por eso, como optometristas, es fundamental que desarrollemos competencias sólidas en la detección temprana y el manejo integral de esta condición.
En España, la prevalencia alcanza el 3.4% en población mayor de 65 años, con proyecciones que indican un aumento del 25% para 2030 debido al envejecimiento poblacional [2]. Esta realidad demográfica nos obliga a estar preparados para identificar los signos iniciales, clasificar adecuadamente la severidad y establecer protocolos de seguimiento que permitan preservar la función visual el mayor tiempo posible.
La DMAE no es una entidad única, sino un espectro de cambios degenerativos que afectan a la mácula, específicamente el complejo epitelio pigmentario de la retina-membrana de Bruch-coriocapilar. Entender esta fisiopatología resulta crucial para interpretar correctamente los hallazgos clínicos y tomar decisiones apropiadas sobre derivación y seguimiento.
La DMAE presenta dos formas principales: atrófica (seca) y neovascular (húmeda), cada una con características clínicas, pronóstico y manejo diferentes. La detección precoz de la forma neovascular es crítica, ya que el tratamiento anti-VEGF puede preservar y ocasionalmente mejorar la función visual cuando se inicia de forma temprana.
Esta miniguía proporciona un enfoque sistemático para la evaluación, clasificación y manejo optométrico de DMAE, enfatizando la importancia de la derivación oportuna y el seguimiento longitudinal.
FACTORES DE RIESGO
Identificar correctamente los factores de riesgo para DMAE es una herramienta fundamental para estratificar a nuestros pacientes y establecer protocolos de seguimiento personalizados. La comprensión de estos factores nos permite no solo predecir quién tiene mayor probabilidad de desarrollar la enfermedad, sino también educar a nuestros pacientes sobre modificaciones del estilo de vida que pueden influir en la progresión.
Estos factores se clasifican en dos categorías principales: aquellos inherentes al individuo que no pueden modificarse, como la edad y la predisposición genética, y aquellos relacionados con el estilo de vida y el ambiente que sí pueden ser objeto de intervención.
La edad sigue siendo el factor de riesgo más potente que conocemos. Mientras la DMAE temprana puede aparecer ocasionalmente en la quinta década de vida, la forma avanzada es poco prevalente antes de los 65 años. Esta relación con la edad no es lineal; cada década después de los 50 años prácticamente duplica el riesgo, lo que explica por qué vemos una explosión de casos en nuestras consultas conforme la población envejece.



CLASIFICACIÓN DE DMAE
La clasificación de DMAE ha evolucionado considerablemente en las últimas décadas. Inicialmente utilizábamos sistemas relativamente simples basados en la presencia o ausencia de drusas, pero la comprensión actual de la enfermedad nos ha llevado a adoptar clasificaciones más sofisticadas que mejor reflejan el riesgo de progresión y las implicaciones terapéuticas [3].
Clasificación Clínica Simplificada (AREDS)
En la práctica diaria, pensamos que la clasificación simplificada de AREDS (Age-Related Eye Disease Study) sigue siendo la más útil para la comunicación con pacientes y otros profesionales de la visión [4]. Este sistema se basa en la presencia, tamaño y características de las drusas, así como en las alteraciones del epitelio pigmentario de la retina (EPR). Esta clasificación está asociada a un riesgo de progresión que ayuda a guiar las decisiones terapéuticas y determina la frecuencia de seguimiento requerida en cada paciente.
- DMAE Temprana
- Drusas medianas (63-124 μm) en área macular sin alteraciones pigmentarias
- Alteraciones pigmentarias mínimas del EPR
- Agudeza visual generalmente preservada
- Test de Amsler normal o alteraciones mínimas
- Asintomática en la mayoría de los casos
- Riesgo bajo de progresión a formas avanzadas [12]
- DMAE Intermedia
-
- Drusas grandes (≥125 μm) o drusas medianas asociadas a alteraciones pigmentarias [3]
- Alteraciones pigmentarias del EPR (hipo/hiperpigmentación)
- Síntomas visuales ocasionales
- Puede haber disminución leve de agudeza visual
- Metamorfopsias ocasionales en Rejilla de Amsler
- Riesgo moderado de progresión (12% a 5 años) [12]

- DMAE Avanzada
-
- Forma Seca (Atrofia Geográfica)
-
-
- Áreas bien delimitadas de atrofia del EPR
- Pérdida de fotorreceptores suprayacentes
- Progresión relativamente lenta
- Escotomas centrales o paracentrales
-

-
- Forma Húmeda (Neovascular)
-
-
- Neovascularización coroidea (NVC) activa
-
- Exudación, hemorragias retinianas o subretinianas
- Desprendimiento del EPR o de la retina neurosensorial
-
- Progresión rápida en ausencia de tratamiento
- Pérdida visual central severa
- Metamorfopias y escotomas
- Neovascularización coroidea (NVC) activa
-

RIESGO DE PASAR A DMAE AVANZADA EN 5 AÑOS
Riesgo de pasar a DMAE avanzada en 5 años
Según el Age-Related Eye Disease Study (AREDS), es posible estratificar el riesgo de un paciente de evolucionar hacia una DMAE avanzada. La siguiente tabla cuantifica la probabilidad a 5 años, basándose en la presencia de factores de riesgo clave como la existencia de drusas grandes y/o la presencia de anomalías en el epitelio pigmentario de la retina.

CLASIFICACIÓN POR LOCALIZACIÓN

EVALUACIÓN CLÍNICA OPTOMÉTRICA
La evaluación de un paciente con sospecha de DMAE requiere un enfoque sistemático que se ha ido progresando a lo largo de los años. No se trata simplemente de medir la agudeza visual y examinar el fondo de ojo; necesitamos una evaluación exhaustiva que incluya función visual, morfología macular y factores de riesgo sistémicos. Esta aproximación integral nos permite no solo detectar la condición, sino también establecer un pronóstico y plan de seguimiento apropiados.
Muchos pacientes en estadios iniciales de DMAE mantienen una agudeza visual aparentemente normal en la consulta, pero experimentan dificultades significativas en su vida diaria. Por eso, la anamnesis dirigida y las pruebas funcionales específicas son tan importantes como el examen morfológico de la mácula.
ANAMNESIS DIRIGIDA
La historia clínica debe enfocarse en síntomas específicos de disfunción macular: metamorfopsias (líneas onduladas), micropsias (objetos más pequeños), dificultad para leer, reconocer caras, dificultad en la conducción o en el uso de dispositivos electrónicos, necesidad de mayor iluminación, y escotomas centrales. La historia familiar de DMAE, especialmente en familiares de primer grado, incrementa significativamente el riesgo de padecer la enfermedad.
Es fundamental indagar sobre la evolución temporal de estos síntomas, ya que los cambios agudos pueden indicar conversión a la forma neovascular.
PRUEBAS OPTOMÉTRICAS ESPECÍFICAS
La evaluación optométrica de pacientes con sospecha o diagnóstico de DMAE requiere un enfoque sistemático y multifacético que va más allá de la simple medición de agudeza visual.
Proponemos un protocolo específico que combine evaluación morfológica con pruebas funcionales que reflejen el impacto real de la enfermedad en la vida del paciente. Cada prueba aporta información complementaria que, interpretada en conjunto, nos proporciona una imagen completa del estado macular y su funcionalidad. Es fundamental que el optometrista comprenda las limitaciones de cada prueba y las interprete en el contexto clínico apropiado para optimizar el cuidado del paciente. La combinación de estas evaluaciones permite monitorizar la progresión de la enfermedad y evaluar la respuesta al tratamiento aplicado por el oftalmólogo.
Agudeza Visual
- Medición con optotipos de alto contraste (ETDRS preferiblemente)
- Agudeza visual con su corrección habitual
- Evaluación de agudeza visual de cerca
- Agudeza visual con agujero estenopeico
- Evaluación en condiciones de baja iluminación
- Agudeza visual con corrección óptima y filtros selectivos
- Documentar cualquier asimetría entre ojos
- Documentación de cambios progresivos en posterior seguimiento
Sensibilidad al Contraste
- Especialmente sensible en estadíos tempranos
- Utilizar test Pelli-Robson o Test digitales
- Evaluar en diferentes frecuencias espaciales
- Correlaciona mejor con función visual que AV estándar
Test de Amsler
- Evaluación de metamorfopsias, escotomas o distorsiones
- Selección de rejilla adecuada
- Prueba monocular a 30 cm.
- Documentación de alteraciones específicas (localización, extensión)
- Educación del paciente para automonitorización en casa
- Limitaciones: baja sensibilidad para DMAE temprana
Oftalmoscopía, Biomicroscopía, Retinografía
- Biomicroscopía: Examen estereoscópico de mácula con lente de +78D o +90D
- Retinografía: Documentación objetiva para seguimiento
- Identificación y clasificación de drusas (tamaño, distribución, características)
- Evaluación de alteraciones pigmentarias del EPR, áreas de atrofia
- Detección de signos de neovascularización (exudados, hemorragias)
- Autofluorescencia para evaluación del EPR y extensión de las áreas de atrofia
- Comparación con exámenes previos para detectar progresión
OCT macular
- Evaluación de presencia de drusas, alteraciones pigmentarias del EPR
- Detección de signos de neovascularización (exudados, hemorragias)
- Evaluación del EPR y extensión de la atrofia
- Comparación con exámenes previos para detectar progresión
Autofluorescencia del Fondo (FAF)
Esencial en DMAE atrófica, muestra áreas hipoautofluorescentes de atrofia geográfica y bordes hiperautofluorescentes que indican progresión activa.

Estudios (p. ej., Holz et al., 2017) correlacionan los patrones de FAF con tasas de crecimiento de AG (1-2 mm²/año).
MANEJO Y SEGUIMIENTO OPTOMÉTRICO
El manejo optométrico de DMAE requiere un enfoque individualizado que considera no solo el estadio de la enfermedad, sino también factores como la edad del paciente, comorbilidades, capacidad funcional y preferencias personales. El objetivo principal es preservar la función visual existente, ralentizar la progresión cuando sea posible, y optimizar la calidad de vida a través de estrategias de rehabilitación visual.
El optometrista desempeña un papel crucial no solo en la detección inicial, sino en el seguimiento a largo plazo y la educación continua del paciente.
Los pacientes mejor informados sobre su condición y que siguen protocolos de auto-monitorización en casa tienden a tener mejores resultados a largo plazo. Por eso, consideramos que la educación del paciente es tan importante como el seguimiento clínico.
PROTOCOLO DE SEGUIMIENTO POR ESTADÍO
DMAE Temprana
- Seguimiento anual con retinografía de fondo de ojo y OCT macular si es posible
- Educación sobre factores de riesgo modificables
- Suplementación antioxidante AREDS2 si está indicada
- Auto-monitorización con Rejilla de Amsler en casa
DMAE Intermedia
- Seguimiento cada 6 meses con con retinografía de fondo de ojo y OCT macular
- Suplementación AREDS2 si está indicada
- Evaluación funcional detallada
- Auto-monitorización con Rejilla de Amsler en casa
- Educación sobre síntomas de alarma
DMAE Avanzada atrófica
- Seguimiento conjunto con oftalmólogo especialista
- Frecuencia según evolución y tratamientos
- Monitorización de progresión de atrofia
- Rehabilitación visual y ayudas ópticas
- Apoyo psicológico y adaptación funcional
- Vigilancia de desarrollo de forma neovascular en ambos ojos
DMAE Avanzada neovascular
- Seguimiento conjunto con oftalmólogo especialista
- Frecuencia según evolución y tratamientos
- Monitorización de respuesta a tratamiento anti-VEGF
- Evaluación de agudeza visual y función central
- Rehabilitación visual y ayudas ópticas
- Apoyo psicológico y adaptación funcional
ESTRATEGOAS DE MANEJO NO FARMACOLÓGICO
Suplementos nutricionales AREDS2
- Fórmula AREDS2: vitamina C (500mg), vitamina E (400 UI), zinc (80mg), cobre (2mg), luteína (10mg), zeaxantina (2mg) [4] [9]
- Indicada en DMAE intermedia o avanzada en un ojo [4]
- Reducción del 25% en riesgo de progresión a formas avanzadas [4]
Modificación de Factores de Riesgo
- Cesar hábito tabáquico (reducción riesgo 20% en 20 años) [5]
- Dieta rica en antioxidantes y omega-3 (vegetales de hoja verde, pescado azul) [10]
- Protección UV con lentes oftámicas apropiadas o filtros selectivos [5]
- Control de factores de riesgo cardiovascular [5]
Ayudas Ópticas en baja visión y Rehabilitación visual
- Magnificación óptica (lupas, telescopios)
- Filtros selectivos para mejorar contraste
- Sistemas de magnificación electrónicos (CCTV, tablets con magnificación)
- Ayudas con inteligencia artificial (IA)
- Mejora de iluminación
- Entrenamiento en técnicas de visión excéntrica [11]
CRITERIOS DE DERIVACIÓN
La derivación oportuna al oftalmólogo especialista en retina constituye uno de los aspectos más críticos del manejo optométrico de DMAE. El calendario de derivación puede marcar la diferencia entre preservar la visión útil y enfrentar una pérdida visual irreversible, y es un factor determinante, sobre todo, en el pronóstico visual de la forma neovascular.
La comunicación efectiva con el oftalmólogo especialista en retina es igualmente importante. Debemos proporcionar información detallada sobre la evolución temporal de los síntomas, hallazgos específicos y cualquier cambio reciente en la función visual. Esta información facilita la toma de decisiones terapéuticas y asegura continuidad en el cuidado.
Es fundamental que el optometrista comprenda no solo cuándo derivar, sino también a qué tipo de especialista y con qué nivel de urgencia, optimizando así los resultados para el paciente.
Derivación Oftalmológica Urgente (24-48 horas)
- Pérdida repentina de visión
- Metamorfopsias de reciente aparición o empeoramiento súbito
- Escotomas centrales de reciente aparición
- Hemorragias retinianas o sub-retinianas nuevas
- Exudados duros de nueva aparición
- Desprendimiento del EPR o neurosensorial
- Cualquier signo sugestivo de neovascularización coroidea
Derivación Oftalmológica Preferente (2-4 semanas)
- Progresión documentada de drusas o alteraciones pigmentarias
- Drusas grandes blandas confluentes de reciente aparición
- Alteraciones pigmentarias extensas progresivas
- Disminución progresiva de agudeza visual no explicada por otros factores
- Desarrollo de atrofia geográfica
- Paciente candidato a ensayos clínicos
Criterios en el tratamiento oftalmológico (Educación)
- Agudeza visual ≥20/400 en ojo afectado
- Ausencia de atrofia foveal extensa
- Capacidad para seguimiento regular
- En neovascularización coroidea activa con afectación foveal o amenaza foveal (anti-VEGF) [7]
- En atrofia geográfica (terapias emergentes) [6]
- Edema macular secundario (anti-VEGF, corticoides) [8]
Derivación a Otros Profesionales
- Optometrista especialista en baja visión y Rehabilitación visual: DMAE avanzada con limitación funcional significativa
- Psicólogo: Ansiedad o depresión relacionada con pérdida visual
- Trabajador social: Necesidad de adaptaciones domiciliarias o apoyo social
- Nutricionista: Optimización de dieta antioxidante
CONSIDERACIONES ESPECIALES
DMAE y conducción
Los pacientes con DMAE pueden mantener el permiso de conducir si cumplen los requisitos visuales legales, pero debemos evaluar cuidadosamente la función visual en condiciones reales. La sensibilidad al contraste reducida y los escotomas centrales pueden comprometer significativamente la seguridad vial, incluso con agudeza visual aparentemente adecuada.
Aspectos psicosociales
La DMAE avanzada tiene un impacto profundo en la calidad de vida y puede llevar a depresión, aislamiento social y pérdida de independencia. Como optometristas, debemos estar atentos a estos aspectos y facilitar el acceso a recursos de apoyo apropiados.
Nuevas Terapias
El tratamiento de la DMAE está evolucionando rápidamente, con terapias génicas, células madre y nuevos agentes anti-angiogénicos en desarrollo. Mantenerse actualizado sobre estos avances nos permite informar mejor a nuestros pacientes sobre opciones futuras.
Prevención Primaria
Aunque no podemos prevenir completamente la DMAE, sí podemos influir en su progresión. La educación sobre factores de riesgo modificables, especialmente en pacientes con historia familiar o fumadores, puede tener un impacto significativo en la salud visual a largo plazo.
DMAE Unilateral vs Bilateral
Los pacientes con DMAE avanzada unilateral presentan riesgo elevado (43% a 5 años) de desarrollar DMAE avanzada en el ojo contralateral. El seguimiento debe intensificarse, con evaluaciones cada 3-4 meses y educación específica sobre síntomas de alarma. La automonitorización con test de Amsler es especialmente importante en estos casos.
PUNTOS CLAVE PARA LA PRÁCTICA CLÍNICA
- La DMAE es la principal causa de ceguera irreversible en mayores de 50 años en países desarrollados
- La detección temprana y clasificación apropiada son fundamentales para el manejo óptimo. Los protocolos basados en estadios optimizan la detección de progresión y aseguran derivación oportuna
- La rejilla de Amsler debe enseñarse a todos los pacientes con DMAE para auto-monitorización en casa.
- La suplementación AREDS2 está indicada en DMAE intermedia y avanzada
- Cualquier cambio visual agudo requiere derivación urgente por sospecha de DMAE neovascular
- El manejo integral incluye aspectos nutricionales, funcionales y psicosociales
- La educación del paciente sobre factores de riesgo modificables es crucial
- El seguimiento debe ser individualizado según el estadío y riesgo de progresión
- Manejo integral: La combinación de suplementación nutricional, modificación de factores de riesgo y rehabilitación visual mejora los resultados funcionales
- Derivación urgente: El reconocimiento inmediato de signos de DMAE neovascular y derivación en 24-48 horas puede preservar la visión central
Esta miniguía proporciona un marco estructurado para el manejo optométrico integral de DMAE, desde la identificación de factores de riesgo hasta la derivación especializada, optimizando la preservación de la función visual y la calidad de vida del paciente.
REFERENCIAS BIBLIOGRÁFICAS
[1] Wong, W. L., Su, X., Li, X., et al. (2014). Global prevalence of age-related macular degeneration and disease burden projection for 2020 and 2040: a systematic review and meta-analysis. Lancet Global Health, 2(2), e106-116.
[2] Klein, R., Chou, C. F., Klein, B. E., et al. (2011). Prevalence of age-related macular degeneration in the US population. Archives of Ophthalmology, 129(1), 75-80.
[3] Ferris, F. L., Wilkinson, C. P., Bird, A., et al. (2013). Clinical classification of age-related macular degeneration. Ophthalmology, 120(4), 844-851.
[4] Age-Related Eye Disease Study 2 Research Group. (2013). Lutein + zeaxanthin and omega-3 fatty acids for age-related macular degeneration. JAMA, 309(19), 2005-2015.
[5] Chakravarthy, U., Wong, T. Y., Fletcher, A., et al. (2010). Clinical risk factors for age-related macular degeneration: a systematic review and meta-analysis. BMC Ophthalmology, 10, 31.
[6] Holz, F. G., Strauss, E. C., Schmitz-Valckenberg, S., et al. (2014). Geographic atrophy: clinical features and potential therapeutic approaches. Ophthalmology, 121(5), 1079-1091.
[7] Rosenfeld, P. J., Brown, D. M., Heier, J. S., et al. (2006). Ranibizumab for neovascular age-related macular degeneration. New England Journal of Medicine, 355(14), 1419-1431.
[8] Virgili, G., Michelessi, M., Parodi, M. B., et al. (2017). Laser photocoagulation for subfoveal choroidal neovascularisation in age-related macular degeneration. Cochrane Database of Systematic Reviews, 3, CD004204.
[9] Evans, J. R., Lawrenson, J. G. (2017). Antioxidant vitamin and mineral supplements for preventing age-related macular degeneration. Cochrane Database of Systematic Reviews, 7, CD000253.
[10] Chew, E. Y., Clemons, T. E., SanGiovanni, J. P., et al. (2014). Secondary analyses of the effects of lutein/zeaxanthin on age-related macular degeneration progression. JAMA Ophthalmology, 132(2), 142-149.
[11] Sunness, J. S., Gonzalez-Baron, J., Applegate, C. A., et al. (1999). Enlargement of atrophy and visual acuity loss in the geographic atrophy form of age-related macular degeneration. Ophthalmology, 106(9), 1768-1779.
[12] Klein, R., Klein, B. E., Knudtson, M. D., et al. (2007). Fifteen-year cumulative incidence of age-related macular degeneration. Ophthalmology, 114(2), 253-262.